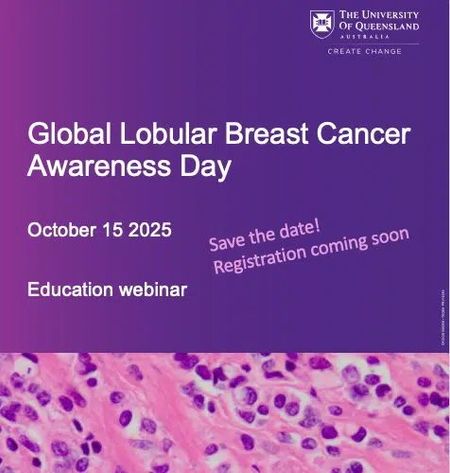

ILC Awareness Day in Brisbane, Oct 15th

Global Lobular Breast Cancer Awareness Day NEXT WEEK .... the online event from Brisbane, Australia.
Using the QR code in the promo below will get you directly into the Zoom Meeting .... apparently there is no need to 'register' .....
Just click on the QR code (or if that doesn't work, this link should get you in):
https://uqz.zoom.us/j/85445087871)